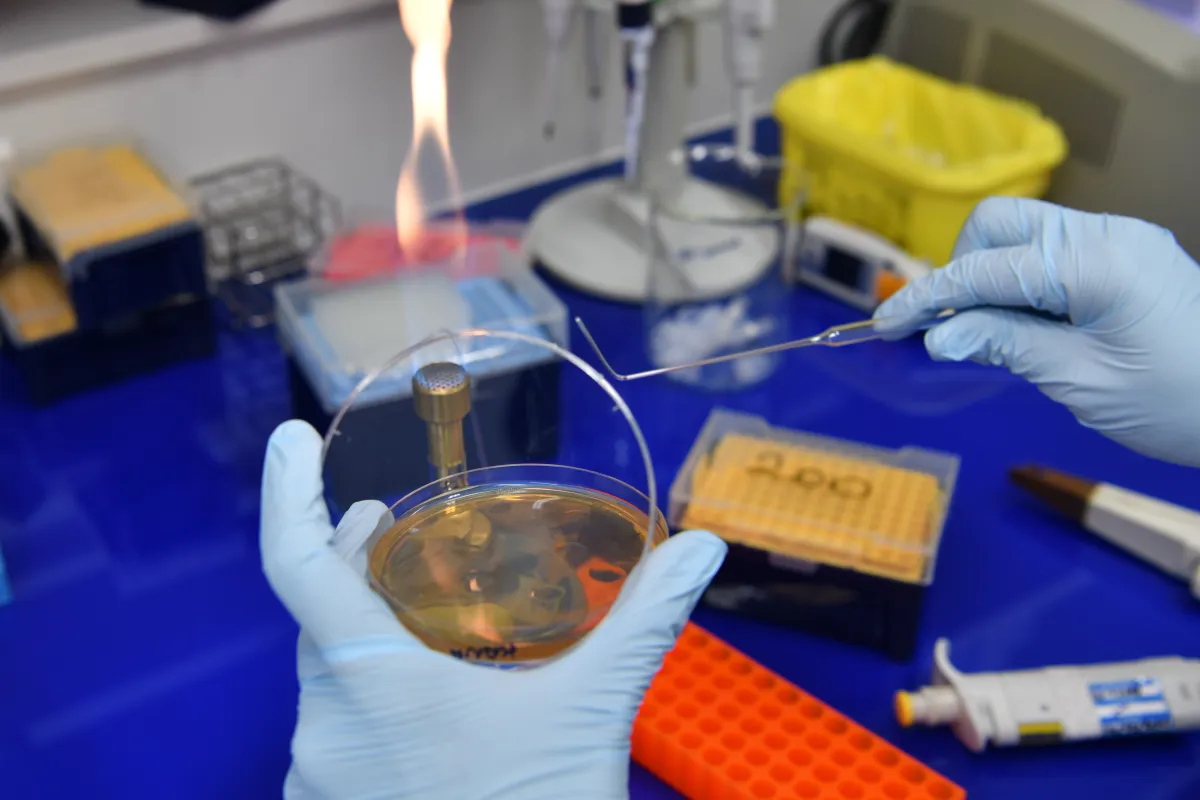

Salvatore Spicuglia Séquencer le génome dans son intégralité
Salvatore Spicuglia, directeur de recherche au laboratoire Theories and approaches of genomic complexity (TAGC), Université Aix-Marseille
Visite du laboratoire « Theories and Approaches of Genomic Complexity » dirigé par Salvatore Spicuglia, au Parc scientifique de Luminy, Université d’Aix-Marseille à Marseille, en octobre 2018.



Le Prix Bettencourt Coups d’élan pour la recherche française 2018 récompense Salvatore Spicuglia, directeur de recherche en biologie génétique, pour ses recherches sur le génome entier.
Percer les secrets de la cellule
S’il est rapide et économique de séquencer un génome entier, les secrets de la cellule sont loin d’être entièrement élucidés. Un grand défi de la génomique consiste à comprendre les mécanismes génétiques et épigénétiques qui régulent l’expression de ces gènes qu’il est si simple de séquencer, et l’impact de leurs variations sur les traits physiologiques et les maladies.
L’équipe de Salvatore Spicuglia, située au laboratoire Theories and approaches of genomic complexity (TAGC) à Marseille, développe depuis ses débuts des méthodes d’investigation sur le génome entier et des outils bioinformatiques. Ces approches servent à étudier la régulation épigénétique et transcriptionnelle durant la différentiation de cellules du système immunitaire, les lymphocytes T.
De nouveaux promoteurs
Récemment, l’équipe a découvert dans ces cellules un nouveau mécanisme de régulation qui remet en question un grand dogme biologique. On pensait jusqu’ici que l’expression d’un gène était contrôlée d’une part par un ou plusieurs promoteurs, proches du gène, et d’autre part par des amplificateurs éloignés. L’équipe de Salvatore Spicuglia a découvert une nouvelle catégorie de promoteurs, baptisés ePromoters, capable d’agir sur les deux plans.
Le soutien de la Fondation
Le soutien du Prix Bettencourt Coups d’élan pour la recherche française permettra à l'équipe de Salvatore Spicuglia d’acquérir l’équipement nécessaire à la transformation à grande échelle de cellules, par la méthode de génie génétique de pointe CRISPR-Cas9. Ce matériel permettra l’intégration de nombreuses mutations dans les cellules étudiées afin de mieux comprendre le fonctionnement de ces ePromoters. Les chercheurs exploreront notamment le rôle des ePromoters dans la réponse inflammatoire impliquée dans les maladies auto-immunes ou les allergies. Les résultats de ces recherches pourraient aider à comprendre l’impact des mutations dans les régions non-codantes de l’ADN, sur la régulation de gènes liés à certaines pathologies.
Salvatore Spicuglia en quelques mots
Après un doctorat portant sur l’expression des récepteurs des lymphocytes T, Salvatore Spicuglia poursuit aux Pays-Bas un post-doctorat durant lequel il explore la transcription chez l’embryon de l’amphibien Xénope.
De retour à Marseille, il se replonge dans la régulation de l’expression génétique dans les lymphocytes T, en s’appuyant sur des méthodes de séquençage à haut débit pour explorer le génome entier. Depuis sa création, son équipe a révélé une dynamique nouvelle de modification des histones, protéines cruciales pour la régulation de l’expression génétique. Elle a mis en évidence une connexion directe entre l’état de compaction de la chromatine et les modes de régulation transcriptionnelle. Plus récemment, l’équipe a fait la découverte révolutionnaire des ePromoters, grâce au développement d’un test de l’activité des amplificateurs de gènes chez les mammifères. Les chercheurs s’appliquent également à implémenter des projets collaboratifs avec des cliniciens, afin d’appliquer ces méthodes à la définition de signatures épigénétiques dans des échantillons de lymphomes humains.
Prix Bettencourt Coups d’élan pour la recherche française
Le Prix Coups d’élan pour la recherche française a été créé par la Fondation en 2000, il a récompensé 78 laboratoires français et plus de 900 chercheurs ont bénéficié de ce prix. Jusqu'en 2021, ce prix était attribué chaque année à quatre équipes de recherche, relevant de l’Inserm et de l’Institut des sciences biologiques du CNRS. La dotation du prix était de 250 000 euros par laboratoire lauréat.
Tous les lauréats du prix